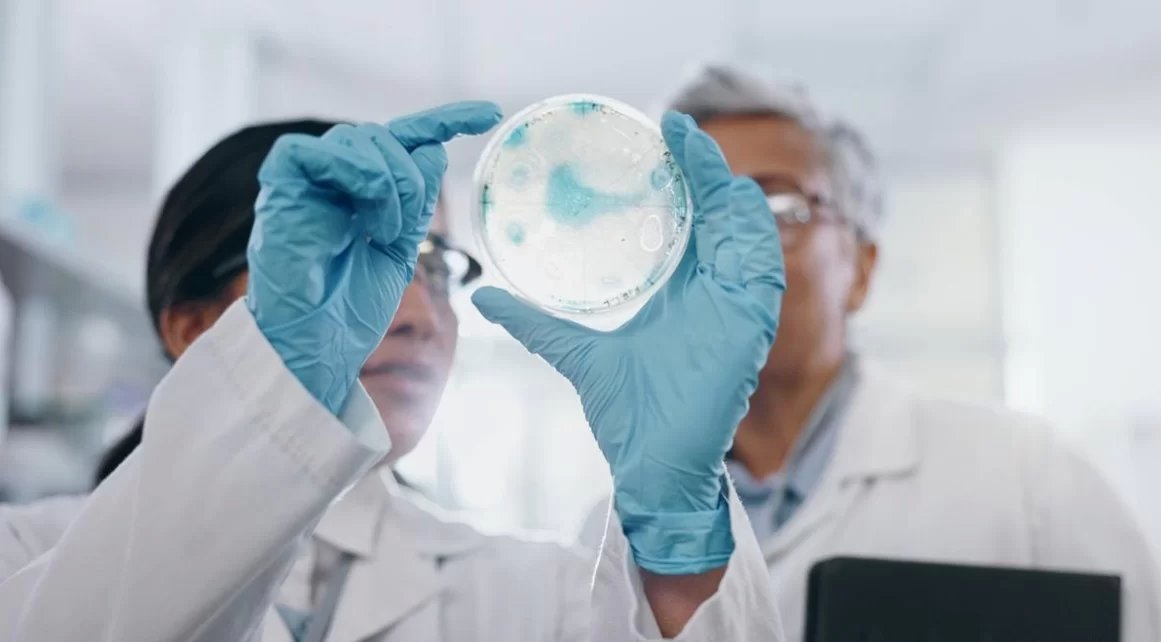

أعلنت وزارة الصحة العامة، في بيان، “انه بتاريخ 14 تشرين الأول، تم ابلاغ الوزارة عن حالة محتملة للكوليرا، على اثره، تم مباشرة التقصي من قبل برنامج الترصد الوبائي من جمع العينات السريرية والبيئية والزيارات الميدانية. وتم تثبيت الحالة بتاريخ 16 تشرين الأول عبر عزل الجرثومة في احدى المختبرات المرجعية وهي ناجمة عن ضمة الكوليرا من النمط 01”.
واشار البيان الى ان “الحالة من الجنسية اللبنانية، وتوجهت الى المستشفى بتاريخ 14 الحالي بسبب اسهال حاد مائي وتجفاف. لا يوجد سفر عند المريضة، وهي من بلدة السمونية في عكار.تقوم الوزارة بتقصي الحالة، وجمع عينات من المخالطين والبحث عن حالات أخرى في محيط المريضة.كما يتضمن التقصي البحث عن تلوث للمياه، وقد تم جمع عدد من عينات المياه من السمونية ومشمش وارسالها الى المختبرات المرجعية.وسيتم تفعيل الخطة الوطنية للكوليرا و المباشرة بإجراءات الاحتواء”.

اترك ردك